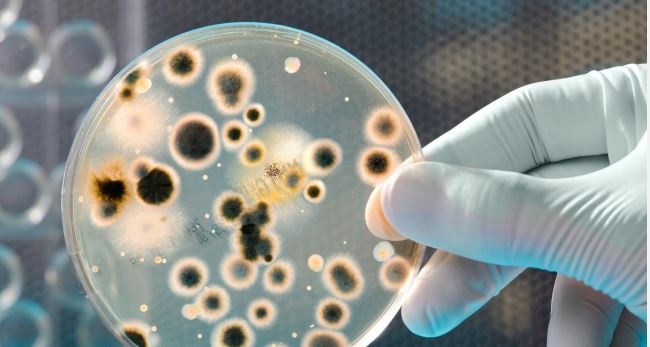

Së fundmi OBSh ka publikuar listën e baktereve më të rrezikshme, rezistentë ndaj antibiotikëve.
Renditja përfshin 24 patogjenë, të cilët bëjnë pjesë në 15 familje të baktereve rezistente ndaj antibiotikëve (AMR).
Rezistenca antimikrobike (AMR) ndodh kur bakteret, viruset dhe parazitët nuk reagojnë më ndaj ilaçeve, duke përkeqësuar sëmundjen dhe duke rritur rrezikun e vdekjes. AMR shkaktohet kryesisht nga përdorimi jo i duhur dhe i tepruar i antimikrobikëve.
OBSh liston ndër bakteret më të rrezikshëm, Acinetobacter, bacilet gram-negative dhe Mycobacterium tuberculosis rezistent ndaj antibiotikut rifampicin. Lista përfshin gjithashtu Enterobacterales dhe Enterobacteria.
Lista e OBSh-së përfshin gjithashtu Neisseria gonorrhoeae dhe Enterococcus faecium, rezistente ndaj antibiotikëve të shumtë, shkruan albinfo.ch.
Këto baktere kërkojnë vëmendje më të madhe, veçanërisht në popullatat vulnerabël, duke përfshirë popullatën pediatrike dhe të moshuar.
Kjo pasi rezistenca ndaj antibiotikëve rrezikon aftësinë tonë për të trajtuar në mënyrë efektive infeksionet me ndikim të lartë si tuberkulozi, duke shkaktuar sëmundje të rënda dhe rritje të shkallës së vdekshmërisë. Provat e reja nga Organizata Botërore e Shëndetësisë (OBSH) tregojnë mbipërdorimin e gjerë të antibiotikëve gjatë pandemisë COVID-19 në mbarë botën, gjë që mund të ketë përkeqësuar përhapjen “e heshtur” të rezistencës antimikrobike (AMR).
Ndërsa vetëm 8% e pacientëve të shtruar në spital me COVID-19 kishin bashkë-infeksione bakteriale që kërkonin antibiotikë, tre nga katër ose rreth 75% e pacientëve janë trajtuar me antibiotikë ‘vetëm në rast se mund të jenë një ndihmë’. Shkalla më e lartë e përdorimit të antibiotikëve u pa tek pacientët me COVID-19 të rëndë, me një mesatare globale prej 81%. Në rastet e lehta ose të moderuara, kishte një variacion të konsiderueshëm midis rajoneve, me përdorimin më të lartë në Afrikë(79%)./Shndeta/
Bie breshër në disa pjesë të Kosovës, publikohen pamje
Hapet në presidencë zyra për viktimat e luftës
Në korrik nis gjykimi ndaj 21 të akuzuarve për masakrën e Re...
KQZ: Vazhdon aplikimi për akreditimin e vëzhguesve dhe media...
Shqipëria, Kosova e Kroacia në diskutime për “industri të pë...
Hamza premton rritje prej 50 për qind të pagave dhe pensione...